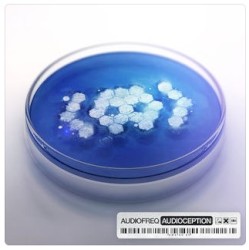
Audioception

Audiofreq
Albums3
- 2016
- Hate It or Love It… This Is HARD With STYLE - OneHeadhunterz & Audiofreq2014
- 2013
EPs9
- 2024
- Hey Adi YogiAudiofreq x Somnia x Shanti People2020
- 2020
- 2020
- 2019
- 2018
- 2015
- 2014
- 2012
Singles44
- GravityCode Black X Audiofreq2026
- 2025
- 2025
- Protect Ya NeckAudiofreq & Soulblast2024
- 2023
- 2023
- Hardcore Maniac (DitzKickz remix)Audiofreq × Lil Texas2023
- DefianceAudiofreq x Geoffrey Day x David Levy feat. Sovereign King2023
- 2023
- 2022
- 2022
- 2022
- 2022
- 2022
- Angel EyezAudiofreq X Crypton2021
- Rub Ur DickAudiofreq X GPF2021
- 2021
- Hardcore ManiacAudiofreq x Lil Texas2021
- Future BassZatox & Audiofreq2021
- The 9th GateAudiofreq & Darksiderz2020
- 2020
- 2019
- 2019
- 2019
- InfiniteAudiofreq & Dave Revan2018
- Dragonblood (Defqon.1 Australia 2016 Anthem)Audiofreq, Code Black & Toneshifterz2016
- 2016
- SplinterTNT & Audiofreq2016
- Back To The UndergroundZatox & Audiofreq2015
- Back to the UndergroundZatox & Audiofreq2015
- 2015
- Wake Up!Organ Donors & Audiofreq2015
- Yerba Diabolika 2K14TNT & Audiofreq2014
- BreakoutHeadhunterz & Audiofreq2014
- 2014
- ScrewdriverTNT Aka Technoboy 'N' Tuneboy And Audiofreq2013
- ForgivenKutski vs. Audiofreq feat. Jenna Lee2012
- RobotScope DJ & Audiofreq2012
- 3 Empty HeadsTNT & Audiofreq2012
- Bring Me DownAudiofreq & The Prophet feat. Teddy2012
- We Are One!The Prophet & Audiofreq2012
- 2012
- 2012
- 2011